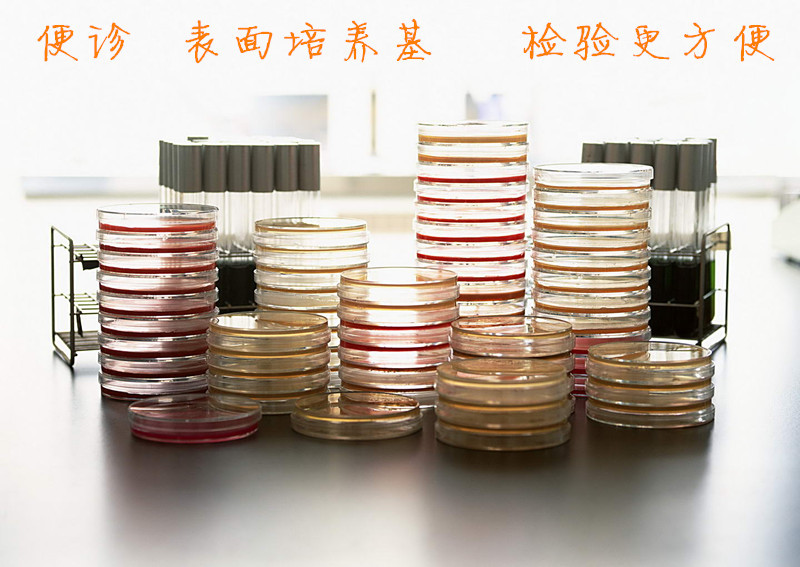
undefined

相关产品推荐更多 >
万千商家帮你免费找货
0 人在求购买到急需产品
- 详细信息
- 询价记录
- 文献和实验
- 技术资料
- 保存条件:
2-8℃,避光储存,拆封后及时放入冰箱冷藏
- 保质期:
半年
- 英文名:
Medium
- 库存:
56235
- 供应商:
南京便诊
三层真空包装

| 为什么选择南京便诊? 主人,看到下面这些。你会喜欢上我的哦!
我从流水线上诞生,我的兄弟姐妹都是 一下流水线,就被包的严严的(常规收缩包 双胞胎,长的很像哦 装/真空包装两种),我都快憋死了……
——让你很容易看到我,不再让你的眼睛再疲劳
使用后焚烧或高压灭菌后按一般垃圾处理 ————我们的环境需要你我的共同努力,不要把我乱丢哦
来听听来自客户的声音
拥有国家生产资质和许可证
专业的、检测生产设备
|

| 【规格】:55mm/25cm2 60mm/25cm2 【优点】:营养丰富,检出率高,保质期长; 【标准】:按照GB标准、SN标准、中国药典、WS标准、YY/T标准、ISO标准、FDA标准、日本标准、USP标准、EP标准、BP标准; 【使用方法】:见说明书或咨询技术人员 【用途】:用于设备、车间、人员、包装材料等表面微生物的测定 【保存条件】:2-8摄氏度 【保质期】6个月 |
消毒物表真菌检测

普通物表细菌检测



普通物表真菌检测

消毒物表真菌检测


普通物表真菌检测

快递直达

产品齐全

公司有近256种培养基及试剂,规格齐全、品种丰富,公司还再不断的开发新品……
产品基因
把产品做到精益求精,把每一件产品当成艺术品!
公司简介
南京便诊生物科技有限公司是专业生产一次性成品培养基等微生物产品的专业性公司,质量参照最新《中华人民共和国药典》2010年版、《国家食品药品检验标准》和《临床医学检验手册》的产品质量标准及检验方法执行,达到临床试剂要求。公司技术团队通过不断的改进生产工艺及生产设备,使其产品质量不断提高,得到很多新老客户的大力认可,并有很多老客户自发的帮我们介绍客户,在此,我代表我们公司全体人员向你们表示最真诚的感谢,同时我们会更加努力,进一步提高,推动微生物行业的发展,为我们各位检验人员提供方便、快捷、准确的产品
企业方向
提供方便、快乐的微生物产品,南京便诊 只卖方便和快乐!
公司厂房


风险提示:丁香通仅作为第三方平台,为商家信息发布提供平台空间。用户咨询产品时请注意保护个人信息及财产安全,合理判断,谨慎选购商品,商家和用户对交易行为负责。对于医疗器械类产品,请先查证核实企业经营资质和医疗器械产品注册证情况。
- 作者
- 内容
- 询问日期
文献和实验3 ............... 20.0 ml 940 mM (95.00 g/L) NH4 NO3 ............. 20.0 ml 1000 mM (80.04 g/L) KH2 PO4 ............. 12.5 ml 100 mM (13.60 g/L) MgSO4 7H2 O......... 15.0 ml 100 mM (24.65 g/L) CaCl2 7H2 O......... 10.0 ml 300 mM (44.00 g/L) Glycine
成分 邻硝基酚β-D-半乳糖昔(ONPG) 60mg (O-Nitrophenyl-β-D-galactopyranoside) 0.01mol/L磷酸钠缓冲液(pH7.5) 10mL 1%蛋白胨水(PH7.5) 30mL 制法 将ONPG溶于缓冲液内,加入蛋白胨水,以过滤法除菌,分装于10mm×75mm试管,每管0.5mL,用橡皮塞塞紧。 试验方法 自琼脂斜面上挑取培养物1满环接种,于36±1℃培养1~3h和24h观察
.43Kpa灭菌20分钟,取出后趁热将试管倾斜一定角度放置,待琼脂 凝固即成琼脂斜面培养基(图3)。三角烧瓶内培养基冷至50-60℃时在超净台或无菌室内将其倾注于灭菌平皿内(15-20ml),凝固后即成琼脂平板。 图: 琼脂斜面培养基 另外,实际工作中现多使用合成营养琼脂干燥粉末制剂。其方法为:称取41克营养琼脂干燥粉末加入1000ml冷蒸馏水中混合放置10分钟,隔石棉铁丝网微火煮沸使其完全溶解,分装于中试管中(约5~7ml)或三角烧瓶,103.43kPa
技术资料暂无技术资料 索取技术资料





![白色念珠菌[CMCC(F)98001][白假丝酵母]](https://img1.dxycdn.com/2018/0424/200/3273942005864612779-14.jpg!wh200)
![优质单核细胞增生李斯特氏菌[ATCC19114] /冻干粉 标准质控菌株](https://img1.dxycdn.com/2022/0107/367/1990178503542315253-14.jpg!wh200)
![90mm胰酪胨大豆琼脂培养基(TSA)[胰酪大豆胨琼脂培养基]](https://img1.dxycdn.com/2022/0106/537/0911160218945005253-14.png!wh200)
![压力蒸汽灭菌生物指示剂[自含式]ATCC7953](https://img1.dxycdn.com/2018/0319/351/3267249151884585230-14.png!wh200)











